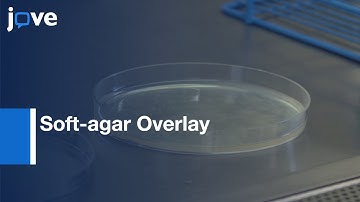
Soft-agar Overlay Screening for Inhibitory Compounds | Protocol Preview

⬇ DOWNLOAD NOW
Kalau muncul iklan pop-up, tutup lalu klik tombol kembali
Download lagu Overlay Assay for Measuring Bacterial Production and Pneumocins effect | Protocol Preview secara gratis hanya untuk keperluan promosi. Dukung artis favorit kamu dengan membeli musik original di iTunes atau platform resmi lainnya.
Soft-agar Overlay Screening for Inhibitory Compounds | Protocol Preview
Soft-agar Overlay Screening for Inhibitory Compounds | Protocol Preview
 Pneumonia Explained
Pneumonia Explained
 Multi-well Format Assay for Studying the Effect of ECM Stiffness | Protocol Preview
Multi-well Format Assay for Studying the Effect of ECM Stiffness | Protocol Preview
 Adherence Assay in Pneumococcal Colonization for Probiotics Estimation | Protocol Preview
Adherence Assay in Pneumococcal Colonization for Probiotics Estimation | Protocol Preview
 Gram Staining Procedure Animation Microbiology - Principle, Procedure, Interpretation | USMLE Step 1
Gram Staining Procedure Animation Microbiology - Principle, Procedure, Interpretation | USMLE Step 1
 Flu vs. Pneumonia #health #youtubeshorts #shorts #shortsfeed #shortvideo #shortsviral #doctor #short
Flu vs. Pneumonia #health #youtubeshorts #shorts #shortsfeed #shortvideo #shortsviral #doctor #short
 Soft Agar Colony Formation Assay to identify inhibitors of Tumors | Protocol Preview
Soft Agar Colony Formation Assay to identify inhibitors of Tumors | Protocol Preview
 Demo of the quick & easy tube-free agar overlay for phage discovery, plaque assays, and purification
Demo of the quick & easy tube-free agar overlay for phage discovery, plaque assays, and purification